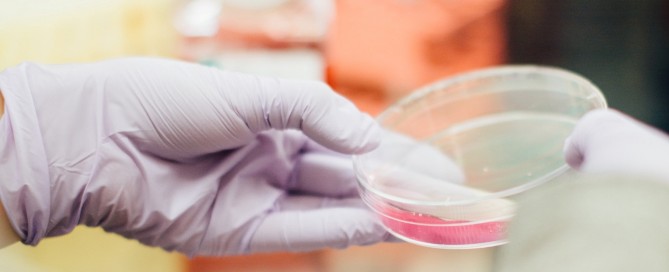
Foto: Drew Hays

U Hrvatskoj od jučer 341 novi slučaj zaraze koronavirusom
U protekla 24 sata zabilježen je 341 novi slučaj pa je broj trenutno oboljelih (aktivnih slučajeva) u Hrvatskoj danas 2.587. Među njima je 299 pacijenata na bolničkom liječenju, od toga su na respiratoru 24 pacijenata. [...]